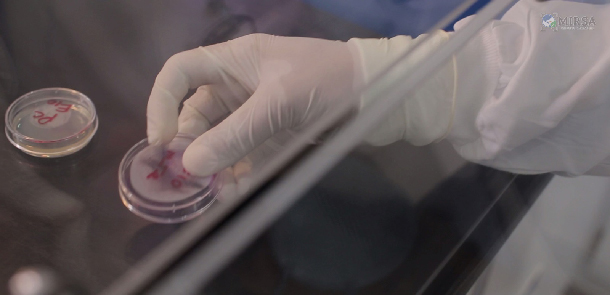

Somos una empresa dedicada a la caracterización y análisis de medios ambientales y ocupacionales, la cual opera bajo altos estándares de calidad, en cumplimiento a métodos internacionales (EPA, OSHA, NIOSH, Standard Methods Of Examination of Water), entre otros.
Somos el primer laboratorio de análisis y caracterización completo de la República Dominicana, brindando servicios de Análisis de niveles de Contaminación, calidad del medio ambiente y salud ocupacional, con la mayor gama de equipos especializados a nivel nacional, con la mayor tecnología disponible a nivel mundial, cada uno con su traceabilidad de respectivas certificaciones.
El Laboratorio Ambiental MIRSA entiende que analistas sólidos y datos analíticos legalmente defendibles, es el elemento más crítico para el éxito de su proyecto ambiental y ocupacional. Garantizar la calidad de resultados es el objetivo y meta primaria de nuestro Laboratorio Ambiental MIRSA.
- Un nivel superior de servicio completo
- Ultima tecnología en equipamientos
- Estabilidad a largo plazo como proveedor de servicios ambientales.
- El compromiso inquebrantable de nuestra solida institución.
- Los servicios que siguen el ciclo de vida de un proyecto, desde la planificación inicial, la gestión de proyectos, la ejecución, la presentación de informes de resultados, y la disposición de la muestra final.
- Experiencia técnica avanzada de Gerentes de Servicio al Cliente y Técnicos Certificados
- Servicios de campo - Muestreo In-Situ. - Laboratorios Móviles
Análisis Fisicoquímicos y Microbiológicos de agua:
- Calidad de Agua Potable
- Descargas de Aguas Residuales
- Calidad de Agua de superficie
- Calidad de Aguas subterráneas
Caracterizaciones de Emisiones Atmosféricas:
- Evaluación Isocinetica – Material Particulado PST- (METHOD 1 – 5 USEPA)
- Emisiones de gases – (SO2, NO2, NO, NOX, CO, H2S, HC, HCL) – (EPA PORTABLE ANALYZERS APROVED)
- Emisiones de Metales (Plomo, Mercurio), etc.
- Emisión Vehicular (HC, Opacidad Lineal) ASTM METHOD
Análisis de Calidad De Aire Ambiental y Ocupacional:
- Evaluación de PST, PM-10, PM-2.5
- Evaluación de Polvo Total y Respirable (OSHA/NIOSH METHOD)
- Evaluación De Contaminantes Específicos (VOC, NO2, SO2, OZONO, Solventes etc.).
- Caracterizaciones del aire ambiental (Metales, Contaminantes etc.)
Validaciones de Clean Room:
- Validaciones Microbiológicas De Superficies y áreas
- Validaciones De Aire comprimido
- Validaciones de Partículas en Cuartos Limpios.
Análisis de Emisiones Sónicas:
- Evaluación de Ruido Ambiental y Ocupacional
Análisis Ocupacionales Específicos:
- Dosimetría de Ruido (% DOSE)
- Análisis de Estrés Térmico
- Análisis de Vibración
- Análisis de Iluminación
Análisis FULL RCRA
- Caracterizaciones de Sustancias y Materiales
